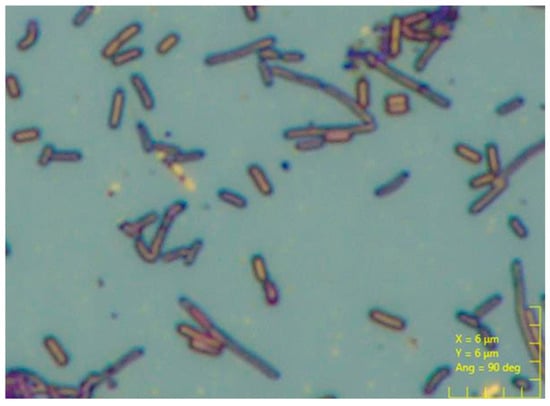

Abstract
Traditional soil stabilization methods, including cement and chemical grouting, are energy-intensive and environmentally harmful. Microbial-induced carbonate precipitation (MICP) technology offers a sustainable alternative by utilizing microorganisms to precipitate calcium carbonate, binding soil particles to improve mechanical properties. However, the application of MICP technology in soil stabilization still faces certain challenges. First, the mineralization efficiency of microorganisms needs to be improved to optimize the uniformity and stability of carbonate precipitation, thereby enhancing the effectiveness of soil stabilization. Second, MICP-treated soil generally exhibits high fracture brittleness, which may limit its practical engineering applications. Therefore, improving microbial mineralization efficiency and enhancing the ductility and overall integrity of stabilized soil remain key issues that need to be addressed for the broader application of MICP technology. This study addresses these challenges by optimizing microbial culture conditions and incorporating polyethylene fiber reinforcement. The experiments utilized sandy soil and polyethylene fibers, with Bacillus pasteurii as the microbial strain. The overall experimental process included microbial cultivation, specimen solidification, and performance testing. Optimization experiments for microbial culture conditions indicated that the optimal urea concentration was 0.5 mol/L and the optimal pH was 9, significantly enhancing microbial growth and urease activity, thereby improving calcium carbonate production efficiency. Specimens with different fiber contents (0% to 1%) were prepared using a stepwise intermittent grouting technique to form cylindrical samples. Performance test results indicated that at a fiber content of 0.6%, the unconfined compressive strength (UCS) increased by 80%, while at a fiber content of 0.4%, the permeability coefficient reached its minimum value (5.83 × 10−5 cm/s). Furthermore, microscopic analyses, including X-ray diffraction (XRD) and scanning electron microscopy with energy-dispersive spectroscopy (SEM–EDS), revealed the synergistic effect between calcite precipitation and fiber reinforcement. The combined use of MICP and fiber reinforcement presents an eco-friendly and efficient strategy for soil stabilization, with significant potential for geotechnical engineering applications.
1. Introduction
Soil stabilization is a critical aspect of sustainable land management, particularly in addressing challenges such as desertification, land degradation, and biodiversity loss [1,2]. These issues are central to the 17 Sustainable Development Goals by the United Nations, which aim to protect, restore, and promote the sustainable use of terrestrial ecosystems. Effective soil stabilization helps mitigate the adverse effects of soil erosion, improves soil fertility, and supports the rehabilitation of degraded lands, thereby enhancing ecosystem health and resilience [3]. By stabilizing soils, we can prevent further degradation of valuable land resources, safeguard biodiversity, and promote the sustainable management of natural habitats, which are essential for the well-being of both human beings and our planet [4]. The complexity of soil stabilization stems from the need to address multifaceted issues related to soil strength, stability, deformation, and seepage, which renders it one of the most challenging problems within the domain of construction engineering [5]. Sandy soils, characterized by their composition of fine mineral grains, present inherent deficiencies and potential issues when utilized as building foundations in construction. Their physical properties, including high permeability, low cohesion, loose structure, and elevated porosity, contribute to these challenges [6,7]. In terms of stability and load-bearing capacity, unconsolidated loose sandy soils exhibit inadequate stability and low load-bearing capacity. As a result, foundations may experience uneven settlement under applied loads, which can lead to structural cracking or tilting, thereby impacting the stability, structural safety, and functional performance of the building [8]. Consequently, in the construction industry, the enhancement and stabilization of sandy soils are crucial for effectively improving engineering quality and safety.
Currently, enhancing the physical and mechanical properties of soils through the use of additives has become a significant area of research within the domain of soil stabilization. Traditional methods for soil stabilization typically involve the injection of grouting materials, which are used to reinforce the soil [9,10,11]. The effectiveness of grouting operations is highly dependent on the type and quality of the grouting materials employed, which can be broadly categorized into two types: cement-based grouts and chemical grouts, including those based on epoxy resins, polyurethane, and methyl methacrylate [12,13,14]. However, recent studies have increasingly revealed several limitations associated with conventional soil stabilization techniques. These limitations include high energy consumption, low efficiency, and the potential for secondary pollution [15,16]. Specifically, cement, a prevalent stabilizing material, is associated with high energy demands and substantial carbon dioxide emissions. The processes of grinding and calcination involved in cement production consume significant amounts of energy and result in considerable greenhouse gas emissions [17,18,19,20]. For instance, the production of one ton of cement clinker is estimated to emit approximately 0.83 tons of carbon dioxide [21], positioning cement production as a significant contributor to global warming. Additionally, other commonly used chemical construction materials, such as epoxy resins, acrylamide, phenolic resins, and polyurethane, often contain components that are detrimental to the environment. Some of these materials may even include toxic substances that pose risks to the surrounding soil, groundwater, and mineral resources, as well as to flora, fauna, and human health [22,23,24]. As a result, both cement and other chemical grouting materials can cause severe environmental and ecological damage during their production and use. Given these concerns, there is an urgent need to investigate and develop novel, environmentally friendly methods and materials for soil stabilization.
Microbial-induced carbonate precipitation emerges as an innovative, eco-friendly alternative that uses biological processes to enhance soil properties while aligning with global commitments to sustainable development and environmental restoration [25,26]. MICP is an emerging biological mineralization technique [27], and the core principle of this technology involves microorganisms producing carbonate ions through their metabolic processes. These carbonate ions then react with calcium ions present in the environment, resulting in the rapid formation of calcium carbonate [28,29]. In the field of soil stabilization, the precipitated calcium carbonate has the capacity to bind soil particles and fill voids within the soil matrix, thereby offering substantial potential for enhancing soil properties. Chu et al. [30] employed microorganisms with high urease activity to perform MICP treatment on sandy soils. The results demonstrated a significant reduction in the permeability of the stabilized sands and a notable increase in their strength. Jian et al. [31] found through experimental research that calcium carbonate precipitates induced by microorganisms adhered to the surfaces of sand particles, effectively binding coarse and fine particles together. This not only improved the strength of the sand but also significantly enhanced its resistance to erosion. Chen et al. [32] explored the effects of MICP treatment on the permeability and mechanical properties of calcareous sands. Their results indicated that the calcite binding and filling effects improved both the mechanical properties and the impermeability of the soil. Additionally, Shan et al. [33] applied MICP technology to calcareous sands and, through cyclic triaxial tests, observed that microbial activity promoted the formation of calcium carbonate binders, which reduced excess pore water pressure and axial strain, thereby increasing the soil’s strength and resistance to liquefaction. Compared to traditional soil stabilization methods, MICP offers ecological, environmental, and economic advantages, making it a promising biologically mediated soil improvement technology [34,35,36,37].
Given the substantial application potential and promising outlook of MICP technology in soil stabilization, advancing its implementation in this field has become a crucial endeavor. Therefore, it is essential to conduct research focused on enhancing the effectiveness of MICP-based soil stabilization techniques. In the field of microbial solidified soil, several critical challenges remain, notably the low mineralization efficiency during the stabilization process and the pronounced brittleness of the consolidated soil post-stabilization [38,39]. Mineralization efficiency is primarily reflected in the capacity and extent of MICP, which directly impacts the strength, stability, and overall performance of the stabilized soil. Both microbial activity and the characteristics of the mineralization reaction medium significantly influence microbial mineralization efficiency [39]. Therefore, enhancing microbial mineralization efficiency through research into microbial activity and mineralization reaction media is crucial for improving MICP-based soil stabilization outcomes. In addition, regarding the issue of brittleness in stabilized soils, it is essential to note that calcium carbonate, the binding agent, inherently possesses brittleness. This characteristic becomes especially pronounced when calcium carbonate binds with sand particles. Consequently, the consolidated layer may be susceptible to brittle failure under conditions such as impact, vibration, or localized loading, which can diminish the overall ductility and stability of the structure [40]. Therefore, to address the issue of brittle fracture in MICP-stabilized sandy soils, it is necessary to investigate soil improvement materials to enhance stabilization effectiveness. Fibers, characterized by their high strength, high modulus, and excellent ductility, have unique physical properties that can significantly improve the overall performance of materials. By distributing stress and enhancing durability, fibers have the potential to mitigate the brittleness of MICP-stabilized sandy soils.
This study focuses on enhancing the effectiveness of soil stabilization using MICP technology by improving microbial mineralization efficiency and addressing the brittleness issue in stabilized soils, while minimizing environmental impact. The research includes experiments on optimizing microbial cultivation conditions, mineralization reaction medium, and the effects of fibers on the uniaxial compressive strength and permeability of stabilized sand columns. Microscopic characterization is performed using X-ray diffraction (XRD) and scanning electron microscopy with energy-dispersive X-ray spectroscopy (SEM–EDS) to explore the synergistic stabilization mechanisms of microbes and fibers. The results from this study have broad implications for geotechnical engineering, offering a promising solution for improving the durability and performance of stabilized soils in infrastructure projects, while fostering environmental resilience against climate change.
2. Materials and Methods
2.1. Raw Materials
2.1.1. Sandy Soil and Fiber
The soil used in the experiments is classified as sandy soil according to the construction engineering classification [41], of which the sand content accounts for 90% and the fine soil content accounts for 10%. The particle size of the sand used in the tests was measured using a laser particle size analyzer (Mastersizer 2000, Malvern, UK). Table 1 presents the particle size information of the sandy soil. Figure 1 shows the particle size distribution curve of the sandy soil. The polyethylene fiber chosen for the experiment is a synthetic fiber, which, compared to natural fibers and other fibers (such as polypropylene fiber and glass fiber), exhibits excellent chemical stability and high tensile strength. The good chemical stability of polyethylene fiber provides better durability and anti-aging performance in soil environments, ensuring its long-term stability within the soil matrix, making it suitable for integration with MICP technology. Additionally, the high tensile strength and elastic modulus of polyethylene fiber help to improve the soil’s ductility, evenly distribute stress, and reduce localized stress concentrations, thereby enhancing the compressive strength and crack resistance of the soil, and addressing the brittleness issue in MICP-treated soils. Relevant parameters and physical properties of the fiber are shown in Table 2.

Table 1.
Particle size analysis information of the sandy soil.

Figure 1.
Particle size distribution curve.

Table 2.
Physical properties of the fiber.
2.1.2. Bacteria and Cementation Medium
The bacterial strain used in the experiments is a Gram-positive Bacillus pasteurii, a non-pathogenic species. It thrives under a wide range of environmental conditions, including varying pH, temperature, and salinity, which are often encountered in soil stabilization applications. The cells are rod-shaped, approximately 2 to 3 µm in length, and can grow well in alkaline media at temperatures ranging from 15 to 37 °C. This strain is commonly found in wastewater and soil. The Bacillus pasteurii cultured in the experiment was initially identified using an inverted biological microscope (IX83, OLYMPUS, Tokyo, Japan) and Gram staining technique. The observation results (Figure 2) are consistent with the characteristics of Bacillus pasteurii.
Figure 2.
Microscopic observation of Bacillus bussiae in the Gram staining state.
Before utilizing the microorganisms, they need to be cultured in advance. The culture medium components included beef extract (6 g/L), soybean peptone (10 g/L), urea (30 g/L), and deionized water. The prepared medium was then transferred into wide-mouth Erlenmeyer flasks and sterilized in an autoclave at 121 °C for 20 min. Following sterilization, Bacillus pasteurii was inoculated into the medium under sterile conditions in a laminar flow hood. Finally, the inoculated medium was incubated at 30 °C with shaking at 150 rpm for 24 h.
The cementation medium prepared for the experiments consisted of urea and calcium chloride, and its molar ratio was 1:1. All reagents used in the experiments were sourced from the China National Pharmaceutical Group Chemical Reagent Platform.
2.2. Experimental Design
In the study of enhancing the effectiveness of MICP-based soil stabilization techniques, this research first focused on optimizing microbial cultivation conditions and the formulation of cementation medium to improve microbial mineralization efficiency and, consequently, the stabilization effect. Subsequently, the study investigated the modification of sandy soil by using fibers as additives, exploring the impact of fiber content on the stabilization effect. The evaluation metrics included the unconfined compressive strength and permeability of the stabilized sand columns. Microscopic analyses were performed using XRD and scanning electron microscopy with SEM–EDS to elucidate the mechanism of fiber and microbial synergy in soil stabilization. The composition ratios for each experimental group are detailed in Table 3. The meaning of the percentage of fiber content is presented in Table 3, which refers to the percentage of the sandy soil volume.

Table 3.
Composition ratio of solidified sandy soil column sample.
2.3. Sample Preparation
The sample preparation process is illustrated in Figure 3. For the preparation of cylindrical samples, the initial step involved weighing the required quantities of sandy soil and fibers, followed by thorough mixing. To prevent fiber clumping, the fibers were pre-dispersed prior to mixing. Once the fibers were evenly mixed with the sandy soil, the mixture was layered into a PVC cylindrical mold with an inner diameter of 39 mm and a height of 80 mm. To prevent sandy soil leakage from the mold and avoid erosion at the sample ends during the grouting process, a geotextile was placed at both ends of the mold. The geotextile also ensured uniform distribution of the injected liquid throughout the sample. After the mold was filled with the mixture, grouting was performed using an intermittent stepwise injection technique. A peristaltic pump was used to deliver the bacterial solution and cementation solution into the mold at a constant rate in a stepwise manner to achieve effective binding. During each grouting round, 50 mL of bacterial solution was added first, followed by a 2 h interval to allow for natural penetration, after which 200 mL of cementation solution was added. This process was repeated for four rounds of grouting. To ensure a more uniform distribution and reaction of the bacterial and cementation solutions among the soil particles, and to mitigate the impact of calcium carbonate precipitation at the sample ends that could obstruct the infiltration of the grouting liquid, a bottom-to-top alternating inversion filling technique was employed. The samples, after completing the grouting process, were placed in an oven and dried at a temperature of 60 °C for 24 h. Once dried, the samples were ready for performance testing.

Figure 3.
Sample preparation process.
2.4. Test Methods
2.4.1. Microbial Activity Test
In the experiment, the transmission light of the bacterial solution was measured by a UV-visible spectrophotometer as an indirect indicator of bacterial concentration to evaluate the growth of microorganisms, in which the absorbance (OD600) at a wavelength of 600 nm was used to characterize the concentration of bacterial solution. The activity of urease decomposition by bacteria was measured by a conductivity meter, and the activity was indicated by measuring the speed of urease decomposition of urea [42]. Initially, 45 mL of a 1.1 mol/L urea solution was measured using a graduated cylinder. Then, 5 mL of bacterial suspension was added to this solution and mixed thoroughly. Finally, the conductivity change value of the mixture was measured by the conductivity meter for 5 min. The urease activity can be represented by the following formula:
where represents urease activity in units of ms/cm/min, is the measured conductivity in units of ms/cm, is the time in min, and m denotes the dilution factor.
2.4.2. Calcium Carbonate Production Rate
Regarding the calcium carbonate production rate, the experiment employed the acid washing method [43] to determine the calcium carbonate production. To determine the yield of CaCO3, the bacterial solution was first mixed with the cementation solution in a beaker and allowed to stand for 12 h. The mixture was then filtered using quantitative filter paper, and the resulting precipitate was weighed after drying. To remove substances other than calcium carbonate, the precipitate was washed with 0.1 M hydrochloric acid solution until no significant bubbling was observed. The mixture was filtered again with quantitative filter paper, and the dried precipitate was weighed. The difference between the two weights represented the actual amount of CaCO3 produced (). The theoretical amount of CaCO3 () was calculated based on the chemical reaction equation. The calcium carbonate yield was determined by dividing the actual amount by the theoretical amount, as shown in the following formula:
where represents the yield of calcium carbonate, is the actual amount of calcium carbonate produced in g, and is the theoretical amount of calcium carbonate produced in g.
2.4.3. UCS
The UCS of the samples was tested using a uniaxial compression testing machine under displacement control mode, with the loading rate set to 1 mm/min. The UCS test was conducted following the Standard for Geotechnical Testing Method (GB/T 50123-2019) [44]. Prior to testing, the cylindrical samples were placed in an oven and dried at 60 °C. After drying, the ends of the samples were polished with sandpaper to ensure they were flat and level, thereby reducing the impact of eccentric loading on the unconfined compressive strength measurement. A total of 18 specimens were used for the UCS tests, with 6 variable groups of fiber content ranging from 0% to 1%, each consisting of 3 specimens. The UCS results for each experimental group are represented by the average of the three test results.
2.4.4. Permeability
According to the geotechnical test method standard (GB/T 50123-2019) [44], a simple device for measuring the permeability was created based on the test principle of the variable head method (Figure 4). The device consisted of a transparent silicone hose, a scale, a Brinell funnel, and an iron frame. The silicone hose, Brinell funnel, and sample were sealed together. The test was conducted by gradually adding distilled water to the transparent silicone hose. Due to gravity, the distilled water entered the soil from the bottom of the sample. After a period of time, water seeped through the top of the sample and accumulated until it overflowed from the top of the pipe. At this point, distilled water was added to the silicone hose to the appropriate height, after which the addition was stopped. The height difference between the concave liquid level in the hose and the upper end of the PVC pipe (overflow surface) was recorded. After an interval of time , the height difference between the concave liquid level in the silicone hose and the overflow surface was recorded. The formula for calculating the permeability coefficient of the sample is provided as follows:
where is the permeability coefficient of the sample in cm/s, is the cross-sectional area of the silicone hose in cm2, is the height of the sample in cm, is the cross-sectional area of the sample in cm2, is the initial head height in cm, and is he final head height in cm.

Figure 4.
Permeability test device.
A total of 18 specimens were used for permeability testing, with 6 variable groups of fiber content ranging from 0% to 1%, each consisting of 3 specimens. The permeability coefficient results for each experimental group are represented by the average of the three test results.
2.4.5. XRD
To analyze the white cementing material between the sand grains, phase identification was performed using X-ray diffraction (XRD) with a Smartlab 9 KW instrument (Smartlab, Rigaku, Japan). The XRD analysis was conducted with the following operational parameters: scanning range of 5° to 80°, scanning speed of 4°/min, and a step size of 0.02°. The XRD data were analyzed using Jade 6 software, and the crystal types and compositions were determined by comparing the diffraction patterns with standard PDF cards.
2.4.6. SEM–EDS
The cured cylindrical samples were cut into 1 cm3 cubes with smooth surfaces, and their internal microstructure was observed using a scanning electron microscope (SEM) equipped with energy dispersive spectroscopy (EDS) (SU3800, GUI 3D, Hitachi, Tokyo, Japan). The SEM–EDS analysis was conducted at an operating voltage of 20 kV, with magnifications ranging from 50× to 2000×. Prior to SEM–EDS analysis, the samples were gold-coated using a Q150T sputter coater (Quorum, London, UK) to mitigate potential electron charge effects on the sample surfaces, with a current of 20 mA.
3. Results
3.1. Optimization of Microbial Culture Conditions
3.1.1. Influence of Urea Concentration
Figure 5a,b illustrate the effect of urea concentration on the growth of Bacillus pasteurii. The graph indicates that with increasing urea concentration, the OD value and urease activity of Bacillus pasteurii initially increase and then decrease. When the urea concentration is within the range of 0.1–0.5 mol/L, urea has a positive impact on microbial growth. Conversely, when the urea concentration in the culture medium exceeds 0.5 mol/L, there is a notable decrease in both the OD value and the urease activity of Bacillus pasteurii, which adversely affects its growth.

Figure 5.
Effect of urea concentration on the growth status and mineralization efficiency of Bacillus pasteurii. (a) Curve of the OD600 value of Bacillus pasteurii. (b) Curve of urease activity of Bacillus pasteurii. (c) Effect of urea concentration on calcium carbonate production.
Figure 5c shows the effect of urea concentration in the medium on the efficiency of calcium carbonate production. As illustrated in the figure, under conditions where the activity levels of Bacillus pasteurii are similar, the reaction between the bacterial suspension and the gelling solution over one hour shows that the highest calcium carbonate production occurs when the urea concentration is 0.5 mol/L, while the lowest production is observed when the urea concentration is 0 mol/L. Additionally, considering the impact of urea concentration on microbial activity (Figure 5a,b), it is evident that at a urea concentration of 0.5 mol/L, the rate of calcium carbonate formation reaches its maximum while microbial growth remains unaffected. Thus, at this optimal concentration, urea significantly enhances the rate of calcium carbonate production without inhibiting microbial growth and metabolism.
3.1.2. Influence of pH
Figure 6 presents the effect of pH on the growth of Bacillus pasteurii. As shown in the figure, within the alkaline pH range of 7 to 12, both the OD600 value and the urease activity of Bacillus pasteurii initially increase with rising pH but then decrease. The optimal growth of Bacillus pasteurii occurs at pH = 9, where the bacterial metabolic activity is most vigorous and the growth rate is the highest. However, at pH = 12, the growth of Bacillus pasteurii is noticeably inhibited.

Figure 6.
Effect of pH on the growth status of Bacillus pasteurii. (a) Curve of the OD600 value of Bacillus pasteurii. (b) Curve of urease activity of Bacillus pasteurii.
3.1.3. Influence of Inoculum Size
Figure 7 illustrates the impact of inoculation levels on the growth of Bacillus pasteurii. As shown, when the microbial inoculation amounts are 5% or 7.5%, the OD values and urease activity during the early growth phase are notably lower compared to inoculation amounts of 10%, 12.5%, and 15%. However, at inoculation levels of 12.5% and 15%, urease activity significantly decreases after 24 h. A microbial inoculation level of 10% provided the best balance between growth and urease activity.

Figure 7.
Effect of inoculum size on the growth status of Bacillus pasteurii. (a) Curve of the OD600 value of Bacillus pasteurii. (b) Curve of urease activity of Bacillus pasteurii.
3.1.4. Growth Curve Under Optimal Conditions
Through cultivation experiments under varying conditions of urea concentration, pH, and inoculum volume, the optimal growth conditions for Bacillus pasteurii were determined: urea concentration of 0.5 mol/L, pH of 9, and inoculum volume of 10%. The growth curve of Bacillus pasteurii under these optimal conditions is shown in Figure 8. As seen in the figure, the growth of Bacillus pasteurii can be divided into three stages.

Figure 8.
Growth curve of Bacillus pasteurii under optimal culture conditions. (a) Curve of the OD600 value of Bacillus pasteurii. (b) Curve of urease activity of Bacillus pasteurii.
Firstly, from 0 to 24 h is the growth phase, during which the OD value of the culture and the urease activity of Bacillus pasteurii increase with time. In this phase, the growth rate of Bacillus pasteurii is at its highest, with cell division and reproduction occurring exponentially, indicating an active metabolic state. From 24 to 48 h, the OD value and urease activity level off, marking the transition to the stationary phase. As nutrients are consumed and waste products accumulate, the growth rate of Bacillus pasteurii slows down, and a dynamic equilibrium between the rates of growth and death is established. During this phase, the bacteria begin to adjust their metabolic processes in response to environmental changes. After 48 h, the nutrients in the medium become depleted, environmental conditions deteriorate, and the accumulation of waste products and lack of oxygen accelerate bacterial death. At this point, the death rate exceeds the division rate, and the bacteria enter the decline phase. Consequently, the urease activity of the microbes begins to decrease. The slight increase in OD value during this phase is attributed to the accumulation of dead cells and waste products after the microbial population begins to decline.
3.2. Optimization of the Cementing Medium in the Mineralization Reaction
Figure 9a illustrates the effect of cementing medium concentration on both the amount and the rate of calcium carbonate precipitation. As shown in the figure, when the bacterial suspension is mixed with the cementing medium in equal volumes, the rate of calcium carbonate formation decreases with increasing cementing medium concentration. Specifically, when the cementing medium concentration exceeds 1 mol/L, the rate of calcium carbonate precipitation significantly drops.

Figure 9.
Effect of the ratio of cementing medium on the amount and rate of calcium carbonate. (a) Cementing medium concentration. (b) Ratio of dosage of bacterial solution to cementing medium (cementing medium concentration: 1 mol/L).
Figure 9b illustrates the influence of the volume ratio between bacterial suspension and cementing medium on the amount and rate of calcium carbonate precipitation. As shown in the figure, when the cementing medium concentration is 1 mol/L, the CaCO3 precipitation rate decreases with an increasing volume of cementing medium. Specifically, when the volume ratio of bacterial suspension to cementation medium exceeds 1:4, the CaCO3 yield drops significantly to below 90%.
3.3. UCS Results
Figure 10 shows the failure morphology of the samples from the group with no fiber content during the unconfined compressive strength test. It is evident from the figure that the failure mode is typical of brittle failure. During the failure process, due to the applied external force, cracks first appear on the surface of the sandy soil column, forming fracture surfaces and causing localized failure. As the external force continues to increase, the collapse caused by the localized failure extends downward until the entire column becomes unstable and the original structure is completely destroyed. Throughout the entire loading process, sand particles continue to detach due to the formation of fracture surfaces. After brittle failure, the sandy soil column exhibits an irregular failure surface, with large depressions and protrusions. The residual sandy soil after failure becomes loose, with the once relatively compact sand particles dispersing due to the fracture. The remaining sandy soil is seen as scattered individual sand particles, fragments, or clumps.

Figure 10.
Failure morphology of solidified sandy soil column samples without fiber content. (a) Failure process. (b) Residual morphology.
Figure 11 depicts the failure morphology of the samples from the experimental group with 0.6% fiber content during the unconfined compressive strength test. Unlike the sudden fracture of brittle failure, the failure mode here involves more noticeable deformation, characteristic of ductile failure. During the failure process, small cracks first appear in localized areas of the sandy soil column. As the stress increases, these cracks expand along multiple paths, gradually forming larger fissures. The sandy soil gradually loosens, but no rapid collapse occurs. Under the tensile force of the fibers, the sandy soil undergoes a slower failure process. Throughout the failure, the specimen experiences compressive deformation due to the external force. Due to the presence of fibers, the surface of the specimen after failure exhibits a relatively uniform crack distribution, without distinct fracture surfaces. Additionally, the residual sandy soil structure after failure retains a certain degree of integrity, not completely disintegrating, and the sand particles do not experience significant detachment.

Figure 11.
Failure morphology of solidified sandy soil column sample with a fiber content of 0.6%. (a) Failure process. (b) Residual morphology.
Figure 12a presents the influence of fiber content on the strength of the microbial solidified sandy soil samples. The figure indicates that the addition of fiber enhances the effectiveness of microbial solidification. As the fiber content increases, the UCS of the samples initially increases and then decreases. The highest UCS, reaching 2.9 MPa, is observed when the fiber content is 0.6%, representing an approximately 80% increase compared to the sample without fiber. However, it is noteworthy that when the fiber content exceeds 0.6%, a decline in the UCS of the samples is observed. Regarding the internal microstructure of the solidified samples, a comparison of Figure 13 (without fiber) and Figure 14 and Figure 15 (fiber content of 0.6%) reveals that fiber incorporation improves the internal structure of the MICP solidified soil. The addition of fiber reduces the spacing between sand particles and strengthens the inter-particle connections. Figure 16 illustrates the impact of a 1% fiber content on the microscopic structure of the soil. The image shows that excessive fiber content leads to fiber agglomeration and bundling, creating voids between sand particles and introducing defects within the soil.

Figure 12.
Macroscopic performance and microscopic characterization of microbial solidified sandy soil samples. (a) Effect of fiber content on unconfined compressive strength of microbial solidified sandy soil samples. (b) XRD image of cementing material.

Figure 13.
SEM–EDS image of sandy soil sample solidified by microorganisms without fiber. (a) SEM image with 50 times magnification. (b) SEM image with 500 times magnification. (c) SEM image with 2000 times magnification. (d) EDS image of cementing material.

Figure 14.
SEM–EDS image of sandy soil sample solidified by microorganisms with a fiber content of 0.6%. (a) SEM image with 50 times magnification. (b) SEM image with 500 times magnification. (c) SEM image with 2000 times magnification. (d) EDS image of cementing material.

Figure 15.
SEM–EDS image of sandy soil sample solidified by microorganisms with a fiber content of 0.6%. (a) SEM image with 50 times magnification. (b) SEM image with 500 times magnification. (c) SEM image with 2000 times magnification. (d) EDS image of cementing material.

Figure 16.
SEM–EDS image of sandy soil sample solidified by microorganisms with a fiber content of 1%. (a) SEM image with 50 times magnification. (b) SEM image with 500 times magnification.
3.4. Permeability Results
Figure 17 shows the effect of fiber content on the permeability of microbial solidified sandy soil samples, demonstrating that as fiber content increases, the permeability coefficient initially decreases and then increases. The addition of an appropriate amount of fiber positively influences the impermeability performance of the microbial solidified sandy soil. At a fiber content of 0.4%, the permeability coefficient reaches its minimum value of 5.83 × 10−5, representing a reduction of 9.3% compared to the sample without fiber.

Figure 17.
Influence of fiber content on the permeability coefficient of microbial solidified sandy soil samples.
When the fiber content exceeds 0.6%, the permeability coefficient of the samples increases significantly, resulting in a notable decline in impermeability performance. At a fiber content of 1%, the permeability coefficient reaches 1.09 × 10−4, which is 69.5% higher than that of the samples without fiber.
4. Discussion
4.1. Optimization of Microbial Culture Conditions
4.1.1. Influence of Urea Concentration
In MICP technology, urea plays a crucial role by providing essential nutrients for microbial growth and promoting the generation of carbonate ions [45,46]. Suitable urea concentrations benefit the growth and metabolism of Bacillus pasteurii, primarily because urea provides the necessary nitrogen source for microbial growth. Under the action of microbial urease, urea hydrolyzes to form inorganic salts and other nitrogen-containing compounds, which are essential for microbial growth and metabolism, thereby promoting microbial growth [47,48]. Excessive urea inhibits the activity of Bacillus pasteurii because high concentrations of urea lead to extensive hydrolysis, generating ammonia and significantly raising the pH. This extreme alkalinity suppresses microbial metabolic activity and growth and may also interfere with protein synthesis and enzyme activity, thereby impacting the microorganism’s normal physiological functions [42,49,50]. Additionally, at an appropriate concentration, urea as a nutrient in the culture medium can significantly enhance the rate of calcium carbonate formation without affecting microbial growth and metabolism. This is because urea provides the necessary nitrogen source for the growth of Bacillus pasteurii while also enabling the early production of carbonate ions through urease-mediated hydrolysis. As a result, when the bacterial suspension is mixed with the cementation medium, the carbonate ions present in the bacterial suspension can directly react with calcium ions in the cementation medium to form calcium carbonate precipitates. This significantly reduces the time required for urease to hydrolyze urea in the cementation medium, thereby positively impacting the efficiency of mineralization.
4.1.2. Influence of pH
The pH regulates the physiological characteristics, metabolic processes, and activity of bacterial strains [51]. Although Bacillus pasteurii can grow in alkaline environments, extreme alkalinity may adversely affect its growth, including enzyme activity and cell membrane stability [52]. Additionally, research indicates that both acidic and strongly alkaline conditions can disrupt the metabolism and urease production of Bacillus pasteurii, potentially leading to irreversible inactivation of the enzymes produced [52,53].
4.1.3. Influence of Inoculum Size
Low inoculation levels may result in insufficient microbial density, extending the growth cycle and reducing metabolic efficiency [54]. Conversely, higher initial bacterial concentrations can accelerate growth and reproduction. Excessively high inoculation levels may lead to increased competition for resources, rapid nutrient depletion, and premature microbial death [55]. Considering the adverse effects of these extremes on Bacillus pasteurii growth, an inoculation level of 10% is recommended as optimal. This level provides an adequate growth environment for the microbes, maximizes urease activity, accelerates the rate of urea hydrolysis, and increases the speed and quantity of calcium carbonate formation. Additionally, it shortens the microbial cultivation time, enhances the efficiency of microbial soil stabilization, and helps avoid increased material costs associated with over- or under-inoculation, thereby improving the overall economic feasibility of the process.
4.2. Optimization of the Cementing Medium in the Mineralization Reaction
The cementing medium composed of urea and calcium sources plays a crucial role in MICP technology. It contributes to the MICP process by facilitating calcium carbonate precipitation through a combination of chemical reactions and microbial activity [56].
The experimental results indicate that when the cementing medium concentration exceeds 1 mol/L, the rate of calcium carbonate precipitation significantly drops. This decrease may be attributed to the fact that a high cementing medium concentration results in elevated urea levels, which leads to excessive ammonia production and a subsequent increase in pH. Excessive alkalinity can be toxic to microorganisms, adversely affecting their growth and metabolism and inhibiting the calcium carbonate precipitation reaction [39]. Additionally, high concentrations of calcium ions can also inhibit urease activity. This inhibition is likely due to increased osmotic pressure on bacterial cells caused by higher salinity and the potential encapsulation of bacterial cells by calcium ions, which impedes nutrient transport. These changes negatively impact the growth conditions and metabolic rates of microorganisms [57,58].
The experimental results indicate that when the volume ratio of bacterial suspension to cementation medium exceeds 1:4, the CaCO3 yield drops significantly to below 90%. This suggests that at this ratio, the calcium ions provided by the cementation medium are not fully utilized for CaCO3 formation, leading to inefficient use of the cementing medium. When the volume of the bacterial suspension is too low relative to the cementing medium, the insufficient microbial population cannot sustain adequate mineralization reactions, thereby restricting the amount of CaCO3 produced and resulting in wastage of the cementing medium. Conversely, if the volume of the cementing medium is too low, the lack of sufficient reactants inhibits the full expression of microbial mineralization capabilities, thus limiting CaCO3 precipitation.
The proportion of the cementing medium has a significant impact on both the amount and the rate of calcium carbonate precipitation. An optimal cementing medium ratio can provide sufficient reactants while maintaining the optimal activity and survival conditions for microorganisms, thereby enhancing calcium carbonate production efficiency. By optimizing this ratio, effective utilization of the cementing medium can be ensured, which reduces unnecessary material consumption, lowers construction costs, and minimizes negative environmental impacts.
4.3. UCS Results
The main reason fiber incorporation changes the failure mode of the soil from brittle failure to ductile failure is that fibers, by connecting and reinforcing the bonds between soil particles, effectively suppress the rapid propagation of cracks and slow down the crack growth rate [59]. This results in a slower and more gradual development of cracks, preventing the sudden collapse characteristic of brittle failure. On the other hand, the fiber-reinforced soil can disperse stress in multiple directions, forming the parallel development of multiple micro-cracks, which further reduces the brittle fracture caused by the rapid expansion of a single crack [60,61].
The significant enhancement in soil stabilization achieved through the integration of fiber reinforcement and MICP technology can be attributed to several key mechanisms. Firstly, the foundational technology is MICP. Analysis of the internal microstructure and crystallization products of microbial solidified sandy soil samples, as shown in Figure 13, reveals that SEM images indicate the presence of square crystallization products that play a filling and cementing role between sand particles. EDS point analysis of these crystallization products shows that the main elements present are carbon (C), oxygen (O), and calcium (Ca). These findings, supported by XRD analysis (Figure 12b), confirm the crystals as calcite. Therefore, it can be determined that special microorganisms, such as urease-positive bacteria, induce the deposition of calcium carbonate during metabolism. This calcium carbonate acts as a natural cementing material, effectively bonding soil particles, increasing shear strength and compressive strength, and thereby achieving the stabilization effect [62,63]. Secondly, the reinforcing effect of fibers plays a crucial role. Once the soil particles are initially bonded by the cementing material generated by microorganisms, the fibers are evenly distributed throughout the soil structure, acting as a “reinforcing skeleton”. This arrangement effectively disperses and transfers the applied load, reducing local stress concentrations and further enhancing the strength and deformation capacity of the soil [60]. During the reinforcement process, the fiber materials form a structure similar to a “bridge” within the soil under the cementation of calcite crystals (Figure 15). This “fiber bridging” significantly contributes to the development of soil strength [64,65]. The bridging effect of fibers can modify the soil structure, making it more uniform and stable [66]. The network or framework formed by fibers within the soil enhances internal frictional resistance, maintaining a tight arrangement and even distribution of soil particles. This reduces particle migration and loss due to external forces, thereby improving the overall density and stability of the soil structure [67,68]. Moreover, during soil deformation and failure, cracks typically propagate rapidly in regions of stress concentration. The bridging effect of fibers resists crack propagation and slows the rate of crack growth, thereby improving the soil’s toughness and deformation capacity [66,69]. In addition, regarding the synergistic effects of fibers and microorganisms, the presence of fibers provides additional surfaces for microbial attachment and growth, improving bacterial colonization. This enhances the microorganisms’ growth and metabolism within the soil, thereby increasing the efficiency and yield of calcium carbonate precipitation [70,71]. Furthermore, during the MICP process, the calcium carbonate precipitates produced by the microorganisms form additional bonding points between the fiber surfaces and soil particles (Figure 14). The mechanical interlocking between the fibers, wrapped in calcium carbonate, and the sand grains further enhances the bridging effect of the fibers [59,72].
While fiber reinforcement enhances the performance of MICP-treated soils, excessive fiber content adversely affects soil stabilization. When fibers agglomerate in the soil, they interlace and overlap with each other, preventing them from dispersing effectively within the soil and leading to the formation of irregular void structures. These voids are not the pores formed by soil particles but are structural voids created by fiber agglomeration. The structure formed after fiber cohesion is typically irregular and may contain some larger voids. These voids are not individual pores but a porous structure resulting from fiber agglomeration. This structure may include larger gaps and irregular channels, which increase the overall porosity. The size and shape of these irregular voids can vary significantly, leading to a non-uniform increase in soil porosity. Additionally, under normal conditions, fibers may fill the gaps between soil particles, increasing the compaction of the soil. However, when fibers agglomerate, the contact area between the fibers and soil particles is reduced, causing the fibers to be less effective at connecting with the soil particles compared to when they are individually distributed. As a result, the fibers are unable to efficiently fill the soil’s pores, leading to an increase in porosity. The larger voids and pores in fiber agglomeration areas make these regions weak points within the soil [73,74]. When subjected to external forces, these agglomerated regions create stress mismatch zones with the surrounding soil. Such areas are more prone to localized failure or crack propagation, which can lead to a reduction in overall soil strength and an increased risk of structural failure. Additionally, fiber agglomeration hinders the even distribution and diffusion of microorganisms within the soil. This results in a reduced and uneven distribution of the cementing agents produced during microbial stabilization, which affects the interface forces between sand particles and fibers. Consequently, this reduces the uniformity and strength of the stabilized soil [68,75].
4.4. Permeability Results
The improvement in impermeability is attributed to the combined effects of fibers and microorganisms. The fibers provide surfaces for microbial attachment, promoting colonization and proliferation of microorganisms within the soil, which enhances the uniform distribution of microorganisms and the curing reaction throughout the soil. During the microbial solidification process, the cementing materials produced fill the soil’s pores, while the fibers strengthen the filled soil structure, reducing porosity and increasing density. This dual sealing effect effectively reduces pathways for water flow, thereby decreasing the soil’s permeability coefficient [71,76]. However, excessive fiber content leads to clustering and the formation of agglomerates within the soil, resulting in an uneven distribution and the creation of localized high-porosity areas and loose structures [74]. These “sand particle–fiber” binding zones develop more voids and pores, increasing the pathways for water seepage. The presence of larger pores provides more extensive infiltration routes, making it easier for water to permeate through the soil and thereby reducing the overall permeability resistance. These findings underscore the importance of optimizing fiber content for effective soil stabilization. Maintaining an optimal balance between fiber reinforcement and microbial cementation is essential to achieve the best performance in MICP-treated soils.
5. Conclusions
This study demonstrates that the integration of MICP technology and fiber reinforcement provides a promising approach to soil stabilization, combining the ecological advantages of microbial technology with the mechanical benefits of fiber reinforcement. By optimizing microbial growth conditions and appropriately controlling fiber content, the limitations of the MICP technique can be alleviated, thereby further enhancing the soil stabilization effect. The experimental results indicate that the optimal microbial growth conditions, with a urea concentration of 0.5 mol/L and a pH value of 9, can significantly increase the calcium carbonate production. When the polyethylene fiber content is 0.6%, the UCS increases by 80%. Meanwhile, at a fiber content of 0.4%, the soil exhibits the lowest permeability, with a permeability coefficient of 5.83 × 10−5 cm/s. The synergistic effects of calcite precipitation and fiber reinforcement provide a sustainable and effective soil stabilization solution, highlighting the potential for widespread application in geotechnical engineering projects. However, the economic feasibility of scaling up MICP remains a consideration. Future research should focus on further refining the MICP process and exploring the scalability of this technology in real-world construction applications.
Author Contributions
Writing—review and editing, writing—original draft, methodology, funding acquisition, conceptualization, C.W.; writing—review and editing, formal analysis, X.L.; writing—review and editing, methodology, data curation, J.Z.; writing—review and editing, formal analysis, W.W.; formal analysis, resources, X.Q.; writing—review and editing, data curation, L.W.; writing—review and editing, resources, formal analysis, N.S.; writing—review and editing, funding acquisition, supervision, L.Z. All authors have read and agreed to the published version of the manuscript.
Funding
The funding was supported by the CSCEC-PT-015 CSCEC City Renovation and Intelligent Operation Engineering Research Center (Building Health Diagnosis and Treatment), the Hebei Province Higher Education S&T Research Project (CXY2024041), and the S&T Program of Hebei (grant No. E2024202247).
Data Availability Statement
This article encompasses the study’s original contributions. Further inquiries can be addressed to the corresponding author.
Conflicts of Interest
Authors Changjun Wang, Xiaoxiao Li, Jianjun Zhu, Wenzhu Wei and Xinran Qu were employed by the company Beijing Building Research Institute Corporation Ltd. Author Ling Wang was employed by the company China Construction First Group Corporation Limited. The remaining authors declare that the research was conducted in the absence of any commercial or financial relationships that could be construed as a potential conflict of interest.
References
- Xie, M.; Zheng, J.; Dong, J.; Miao, C. Foundation improvement with lattice-shaped diaphragm wall treatment for high embankment culverts on soft foundation. Tunn. Undergr. Space Technol. 2020, 104, 103535. [Google Scholar]
- Long, G.; Li, L.; Li, W.; Ma, K.; Dong, W.; Bai, C.; Zhou, J.L. Enhanced mechanical properties and durability of coal gangue reinforced cement-soil mixture for foundation treatments. J. Clean. Prod. 2019, 231, 468–482. [Google Scholar]
- Keybondori, S.; Abdi, E.; Deljouei, A.; Cislaghi, A.; Shakeri, Z.; Etemad, V. Soil-bioengineering to stabilize gravel roadside slopes in the steep Hyrcanian Forests of Northern Iran. Ecol. Eng. 2025, 214, 107569. [Google Scholar]
- Löbmann, M.T.; Geitner, C.; Wellstein, C.; Zerbe, S. The influence of herbaceous vegetation on slope stability—A review. Earth-Sci. Rev. 2020, 209, 103328. [Google Scholar]
- Naveed, M.; Duan, J.; Uddin, S.; Suleman, M.; Hui, Y.; Li, H. Application of microbially induced calcium carbonate precipitation with urea hydrolysis to improve the mechanical properties of soil. Ecol. Eng. 2020, 153, 105885. [Google Scholar]
- Al-Sanad, H.; Ismael, N.; Nayfeh, A. Geotechnical properties of dune sands in Kuwait. Eng. Geol. 1993, 34, 45–52. [Google Scholar]
- Fabozzi, S.; Porchia, A.; Fierro, T.; Peronace, E.; Pagliaroli, A.; Moscatelli, M. Seismic compression susceptibility in dry loose sandy and silty soil in a seismic microzonation perspective. Eng. Geol. 2020, 264, 105324. [Google Scholar]
- Elipe, M.G.; López-Querol, S. Aeolian sands: Characterization, options of improvement and possible employment in construction—The State-of-the-art. Constr. Build. Mater. 2014, 73, 728–739. [Google Scholar]
- Sánchez-Garrido, A.J.; Navarro, I.J.; Yepes, V. Evaluating the sustainability of soil improvement techniques in foundation substructures. J. Clean. Prod. 2022, 351, 131463. [Google Scholar] [CrossRef]
- Bagriacik, B. Utilization of alkali-activated construction demolition waste for sandy soil improvement with large-scale laboratory experiments. Constr. Build. Mater. 2021, 302, 124173. [Google Scholar]
- Jia, Z.; Yan, C.; Li, B.; Bao, H.; Lan, H.; Liang, Z.; Shi, Y.; Ren, J. Performance test and effect evaluation of guar gum-stabilized loess as a sustainable slope protection material. J. Clean. Prod. 2023, 408, 137085. [Google Scholar] [CrossRef]
- Almajed, A.; Lateef, M.A.; Moghal, A.A.B.; Lemboye, K. State-of-the-art review of the applicability and challenges of microbial-induced calcite precipitation (MICP) and enzyme-induced calcite precipitation (EICP) techniques for geotechnical and geoenvironmental applications. Crystals 2021, 11, 370. [Google Scholar] [CrossRef]
- Niu, C.; Lin, Z.; Fu, Q.; Xu, Y.; Chen, Y.; Lu, L. An eco-friendly versatile superabsorbent hydrogel based on sodium alginate and urea for soil improvement with a synchronous chemical loading strategy. Carbohydr. Polym. 2024, 327, 121676. [Google Scholar] [CrossRef] [PubMed]
- Wang, X.F.; Wang, C.J.; Yue, W.V.; Zhang, Z.J.; Yue, Z.Q. In situ digital testing method for quality assessment of soft soil improvement with polyurethane. J. Rock Mech. Geotech. Eng. 2023, 16, 1732–1748. [Google Scholar] [CrossRef]
- Liu, H.; Zhao, M. Review of ground improvement technical and its application in China. China Civ. Eng. J. 2016, 49, 96–115. [Google Scholar]
- Zhang, Z.; Shi, Z.; Yang, J.; Hao, B.; Hao, L.; Diao, F.; Wang, L.; Bao, Z.; Guo, W. A new strategy for evaluating the improvement effectiveness of degraded soil based on the synergy and diversity of microbial ecological function. Ecol. Indic. 2021, 120, 106917. [Google Scholar] [CrossRef]
- Tan, C.; Yu, X.; Guan, Y. A technology-driven pathway to net-zero carbon emissions for China’s cement industry. Appl. Energy 2022, 325, 119804. [Google Scholar] [CrossRef]
- Hassan, A.; Arif, M.; Shariq, M. Effect of curing condition on the mechanical properties of fly ash-based geopolymer concrete. Appl. Sci. 2019, 1, 1–9. [Google Scholar] [CrossRef]
- Busch, P.; Kendall, A.; Murphy, C.W.; Miller, S.A. Literature review on policies to mitigate GHG emissions for cement and concrete. Resour. Conserv. Recycl. 2022, 182, 106278. [Google Scholar] [CrossRef]
- UN Environment; Scrivener, K.L.; John, V.M.; Gartner, E.M. Eco-efficient cements: Potential economically viable solutions for a low-CO2 cement-based materials industry. Cem. Concr. Res. 2018, 114, 2–26. [Google Scholar] [CrossRef]
- Xu, D.; Cui, Y.; Li, H.; Yang, K.; Xu, W.; Chen, Y. On the future of Chinese cement industry. Cem. Concr. Res. 2015, 78, 2–13. [Google Scholar] [CrossRef]
- Achal, V.; Kawasaki, S.J. Biogrout: A Novel Binding Material for Soil Improvement and Concrete Repair. In Frontiers in Microbiology; Frontiers Media SA: Lausanne, Switzerland, 2016; p. 314. [Google Scholar]
- Ramos, O.; Kwon, T.-H. Development of bio-grout injection strategy and design guide using reactive transport model for field-scale soil improvement based on microbially induced calcium carbonate precipitation (MICP). Geomech. Energy Environ. 2023, 36, 100509. [Google Scholar]
- Zheng, R.; Feng, X.; Zou, W.; Wang, R.; Yang, D.; Wei, W.; Li, S.; Chen, H. Converting loess into zeolite for heavy metal polluted soil remediation based on “soil for soil-remediation” strategy. J. Hazard. Mater. 2021, 412, 125199. [Google Scholar] [PubMed]
- Payan, M.; Sangdeh, M.K.; Salimi, M.; Ranjbar, P.Z.; Arabani, M.; Hosseinpour, I. A comprehensive review on the application of microbially induced calcite precipitation (MICP) technique in soil erosion mitigation as a sustainable and environmentally friendly approach. Results Eng. 2024, 24, 103235. [Google Scholar] [CrossRef]
- Wang, Y.; Sun, X.; Miao, L.; Wang, H.; Wu, L.; Shi, W.; Kawasaki, S. State-of-the-art review of soil erosion control by MICP and EICP techniques: Problems, applications, and prospects. Sci. Total Environ. 2024, 912, 169016. [Google Scholar] [CrossRef]
- Zhang, Y.S.; Liu, Y.; Sun, X.D.; Zeng, W.; Xing, H.P.; Lin, J.Z.; Kang, S.B.; Yu, L. Application of microbially induced calcium carbonate precipitation (MICP) technique in concrete crack repair: A review. Constr. Build. Mater. 2024, 411, 134313. [Google Scholar]
- Vaskevicius, L.; Malunavicius, V.; Jankunec, M.; Lastauskiene, E.; Talaikis, M.; Mikoliunaite, L.; Maneikis, A.; Gudiukaite, R. Insights in MICP dynamics in urease-positive Staphylococcus sp. H6 and Sporosarcina pasteurii bacterium. Environ. Res. 2023, 234, 116588. [Google Scholar]
- Prajapati, N.K.; Agnihotri, A.K.; Basak, N. Microbial induced calcite precipitation (MICP) a sustainable technique for stabilization of soil: A review. Mater. Today Proc. 2023, 93, 357–361. [Google Scholar] [CrossRef]
- Chu, J.; Ivanov, V.; Naeimi, M.; Stabnikov, V.; Liu, H.-L. Optimization of calcium-based bioclogging and biocementation of sand. Acta Geotech. 2014, 9, 277–285. [Google Scholar]
- Jiang, N.-J.; Soga, K.; Kuo, M. Microbially induced carbonate precipitation for seepage-induced internal erosion control in sand–clay mixtures. J. Geotech. Geoenviron. Eng. 2017, 143, 04016100. [Google Scholar] [CrossRef]
- Chen, Y.; Han, Y.; Zhang, X.; Sarajpoor, S.; Zhang, S.; Yao, X. Experimental study on permeability and strength characteristics of MICP-treated calcareous sand. Biogeotechnics 2023, 1, 100034. [Google Scholar] [CrossRef]
- Shan, Y.; Zhao, J.; Tong, H.; Yuan, J.; Lei, D.; Li, Y. Effects of activated carbon on liquefaction resistance of calcareous sand treated with microbially induced calcium carbonate precipitation. Soil Dyn. Earthq. Eng. 2022, 161, 107419. [Google Scholar] [CrossRef]
- Ivanov, V.; Stabnikov, V. Construction Biotechnology: Biogeochemistry, Microbiology and Biotechnology of Construction Materials and Processes; Springer: Berlin/Heidelberg, Germany, 2016. [Google Scholar]
- Dejong, J.T.; Soga, K.; Kavazanjian, E.; Burns, S.; Van Paassen, L.; Al Qabany, A.; Aydilek, A.; Bang, S.; Burbank, M.; Caslake, L.F. Biogeochemical Processes and Geotechnical Applications: Progress, Opportunities and Challenges. In Proceedings of the Bio- and Chemo-Mechanical Processes in Geotechnical Engineering: Géotechnique Symposium in Print 2013, London, UK, 3 June 2013. [Google Scholar]
- Liufu, Z.; Yuan, J.; Shan, Y.; Cui, J.; Tong, H.; Zhao, J. Effect of particle size and gradation on compressive strength of MICP-treated calcareous sand. Appl. Ocean Res. 2023, 140, 103723. [Google Scholar] [CrossRef]
- Li, Y.; Li, Y.; Guo, Z.; Xu, Q. Durability of MICP-reinforced calcareous sand in marine environments: Laboratory and field experimental study. Biogeotechnics 2023, 1, 100018. [Google Scholar] [CrossRef]
- Wang, X.; Li, C.; He, J. A highly effective strain screened from soil and applied in cementing fine sand based on MICP-bonding technology. J. Biotechnol. 2022, 350, 55–66. [Google Scholar] [CrossRef]
- Zhang, X.; Wang, H.; Wang, Y.; Wang, J.; Cao, J.; Zhang, G. Improved methods, properties, applications and prospects of microbial induced carbonate precipitation (MICP) treated soil: A review. Biogeotechnics 2024, 100123. [Google Scholar] [CrossRef]
- Shan, Y.; Liang, J.; Tong, H.; Yuan, J.; Zhao, J. Effect of different fibers on small-strain dynamic properties of microbially induced calcite precipitation–fiber combined reinforced calcareous sand. Constr. Build. Mater. 2022, 322, 126343. [Google Scholar] [CrossRef]
- GB/T 50145-2007; Standard for Engineering Classification of Soil. China Architecture & Building Press (CABP): Beijing, China, 2007.
- Whiffin, V.S. Microbial CaCO3 Precipitation for the Production of Biocement. Ph.D. Thesis, Murdoch University Perth, Perth, Australia, 2004. [Google Scholar]
- Chen, L.; Song, Y.; Fang, H.; Feng, Q.; Lai, C.; Song, X. Systematic optimization of a novel, cost-effective fermentation medium of Sporosarcina pasteurii for microbially induced calcite precipitation (MICP). Constr. Build. Mater. 2022, 348, 128632. [Google Scholar]
- GB/T 50123-2019; Standard for Geotechnical Testing Method. China Planning Publishing House: Beijing, China, 2019.
- Sun, Y.; Liu, K.; Sun, D.; Jiang, N.; Xu, W.; Wang, A. Evaluation of urea hydrolysis for MICP technique applied in recycled aggregate: Concentration of urea and bacterial spores. Constr. Build. Mater. 2024, 419, 135366. [Google Scholar] [CrossRef]
- Chen, M.; Li, Y.; Jiang, X.; Zhao, D.; Liu, X.; Zhou, J.; He, Z.; Zheng, C.; Pan, X. Study on soil physical structure after the bioremediation of Pb pollution using microbial-induced carbonate precipitation methodology. J. Hazard. Mater. 2021, 411, 125103. [Google Scholar] [CrossRef]
- Yi, H.; Zheng, T.; Jia, Z.; Su, T.; Wang, C. Study on the influencing factors and mechanism of calcium carbonate precipitation induced by urease bacteria. J. Cryst. Growth 2021, 564, 126113. [Google Scholar] [CrossRef]
- Martinez, B.; DeJong, J.; Ginn, T.; Montoya, B.; Barkouki, T.; Hunt, C.; Tanyu, B.; Major, D. Experimental optimization of microbial-induced carbonate precipitation for soil improvement. J. Geotech. Geoenvironmental Eng. 2013, 139, 587–598. [Google Scholar] [CrossRef]
- Nemati, M.; Greene, E.A.; Voordouw, G. Permeability profile modification using bacterially formed calcium carbonate: Comparison with enzymic option. Process Biochem. 2005, 40, 925–933. [Google Scholar]
- Lauchnor, E.G.; Topp, D.; Parker, A.; Gerlach, R. Whole cell kinetics of ureolysis by Sporosarcina pasteurii. J. Appl. Microbiol. 2015, 118, 1321–1332. [Google Scholar]
- Gat, D.; Ronen, Z.; Tsesarsky, M. Long-term sustainability of microbial-induced CaCO3 precipitation in aqueous media. Chemosphere 2017, 184, 524–531. [Google Scholar]
- Mobley, H.; Island, M.D.; Hausinger, R.P. Molecular biology of microbial ureases. Microbiol. Rev. 1995, 59, 451–480. [Google Scholar]
- Erşan, Y.Ç.; Belie, N.d.; Boon, N. Microbially induced CaCO3 precipitation through denitrification: An optimization study in minimal nutrient environment. Biochem. Eng. J. 2015, 101, 108–118. [Google Scholar]
- Panikov, N.S. Kinetics of Microbial Processes: General Principles. In Encyclopedia of Soils in the Environment, 2nd ed.; Goss, M.J., Oliver, M., Eds.; Academic Press: Cambridge, MA, USA, 2023; pp. 168–185. [Google Scholar]
- Fu, T.; Saracho, A.C.; Haigh, S.K. Microbially induced carbonate precipitation (MICP) for soil strengthening: A comprehensive review. Biogeotechnics 2023, 1, 100002. [Google Scholar]
- Seifan, M.; Samani, A.K.; Berenjian, A. Bioconcrete: Next generation of self-healing concrete. Appl. Microbiol. 2016, 100, 2591–2602. [Google Scholar] [CrossRef]
- Choi, S.G.; Chu, J.; Brown, R.C.; Wang, K.; Wen, Z. Sustainable biocement production via microbially induced calcium carbonate precipitation: Use of limestone and acetic acid derived from pyrolysis of lignocellulosic biomass. Sustain. Chem. 2017, 5, 5183–5190. [Google Scholar]
- Li, D.; Tian, K.; Zhang, H.; Wu, Y.; Nie, K.; Zhang, S. Experimental investigation of solidifying desert aeolian sand using microbially induced calcite precipitation. Constr. Build. Mater. 2018, 172, 251–262. [Google Scholar]
- Tang, C.-S.; Li, H.; Pan, X.-H.; Yin, L.-Y.; Cheng, L.; Cheng, Q.; Liu, B.; Shi, B. Coupling effect of biocementation-fiber reinforcement on mechanical behavior of calcareous sand for ocean engineering. Bull. Eng. Geol. Environ. 2022, 81, 163. [Google Scholar]
- Shu, Y.; Song, Y.; Fang, H.; Wang, D.; Lu, W.; Huang, Y.; Zhao, C.; Chen, L.; Song, X. Fiber-reinforced microbially induced carbonate precipitation (MICP) for enhancing soil stability: Mechanisms, effects, and future prospects. J. Build. Eng. 2024, 94, 109955. [Google Scholar]
- Yetimoglu, T.; Salbas, O. A study on shear strength of sands reinforced with randomly distributed discrete fibers. Geotext. Geomembr. 2003, 21, 103–110. [Google Scholar]
- Gong, L.; Liu, L.; Xu, Y.; Zhu, S.; Hao, T. A discrete element simulation considering calcite crystal shape to investigate the mechanical behaviors of bio-cemented sands. Constr. Build. Mater. 2023, 368, 130398. [Google Scholar]
- Wang, Y.; Soga, K.; Dejong, J.T.; Kabla, A.J. A microfluidic chip and its use in characterising the particle-scale behaviour of microbial-induced calcium carbonate precipitation (MICP). Géotechnique 2019, 69, 1086–1094. [Google Scholar]
- Choi, S.-G.; Wang, K.; Chu, J. Properties of biocemented, fiber reinforced sand. Constr. Build. Mater. 2016, 120, 623–629. [Google Scholar]
- Zeng, H.; Yin, L.-Y.; Tang, C.-S.; Zhu, C.; Cheng, Q.; Li, H.; Lv, C.; Shi, B. Tensile behavior of bio-cemented, fiber-reinforced calcareous sand from coastal zone. Eng. Geol. 2021, 294, 106390. [Google Scholar]
- Li, M.; Li, L.; Ogbonnaya, U.; Wen, K.; Tian, A.; Amini, F. Influence of fiber addition on mechanical properties of MICP-treated sand. J. Mater. Civ. Eng. 2016, 28, 04015166. [Google Scholar]
- Wang, D.-L.; Tang, C.-S.; Pan, X.-H.; Liu, B.; Shi, B. Coupling effect of fiber reinforcement and MICP stabilization on the tensile behavior of calcareous sand. Eng. Geol. 2023, 317, 107090. [Google Scholar]
- Feng, K.; Montoya, B. Influence of confinement and cementation level on the behavior of microbial-induced calcite precipitated sands under monotonic drained loading. J. Geotech. Geoenviron. Eng. 2016, 142, 04015057. [Google Scholar] [CrossRef]
- Liu, J.; Li, X.a.; Li, G.; Zhang, J. Experimental study on the mechanical behaviors of aeolian sand treated by microbially induced calcite precipitation (MICP) and basalt fiber reinforcement (BFR). Materials 2023, 16, 1949. [Google Scholar] [CrossRef] [PubMed]
- Zhao, Y.; Xiao, Z.; Fan, C.; Shen, W.; Wang, Q.; Liu, P. Comparative mechanical behaviors of four fiber-reinforced sand cemented by microbially induced carbonate precipitation. Bull. Eng. Geol. Environ. 2020, 79, 3075–3086. [Google Scholar]
- Imran, M.A.; Gowthaman, S.; Nakashima, K.; Kawasaki, S. The influence of the addition of plant-based natural fibers (Jute) on biocemented sand using MICP method. Materials 2020, 13, 4198. [Google Scholar] [CrossRef]
- Yao, D.; Wu, J.; Wang, G.; Wang, P.; Zheng, J.-J.; Yan, J.; Xu, L.; Yan, Y. Effect of wool fiber addition on the reinforcement of loose sands by microbially induced carbonate precipitation (MICP): Mechanical property and underlying mechanism. Acta Geotech. 2021, 16, 1401–1416. [Google Scholar]
- Lv, C.; Zhu, C.; Tang, C.-S.; Cheng, Q.; Yin, L.-Y.; Shi, B. Effect of fiber reinforcement on the mechanical behavior of bio-cemented sand. Geosynth. Int. 2021, 28, 195–205. [Google Scholar]
- Chaduvula, U.; Viswanadham, B.; Kodikara, J. A study on desiccation cracking behavior of polyester fiber-reinforced expansive clay. Appl. Clay Sci. 2017, 142, 163–172. [Google Scholar]
- Li, G.; Liu, J.; Zhang, J.; Yang, Y.; Chen, S. Shear Strength Behaviors of Aeolian Sand Solidified by Microbially Induced Calcite Precipitation and Basalt Fiber Reinforcement. Materials 2023, 16, 5857. [Google Scholar] [CrossRef]
- Liang, S.; Xiao, X.; Wang, J.; Wang, Y.; Feng, D.; Zhu, C. Influence of fiber type and length on mechanical properties of MICP-treated sand. Materials 2022, 15, 4017. [Google Scholar] [CrossRef]
Disclaimer/Publisher’s Note: The statements, opinions and data contained in all publications are solely those of the individual author(s) and contributor(s) and not of MDPI and/or the editor(s). MDPI and/or the editor(s) disclaim responsibility for any injury to people or property resulting from any ideas, methods, instructions or products referred to in the content. |
© 2025 by the authors. Licensee MDPI, Basel, Switzerland. This article is an open access article distributed under the terms and conditions of the Creative Commons Attribution (CC BY) license (https://creativecommons.org/licenses/by/4.0/).